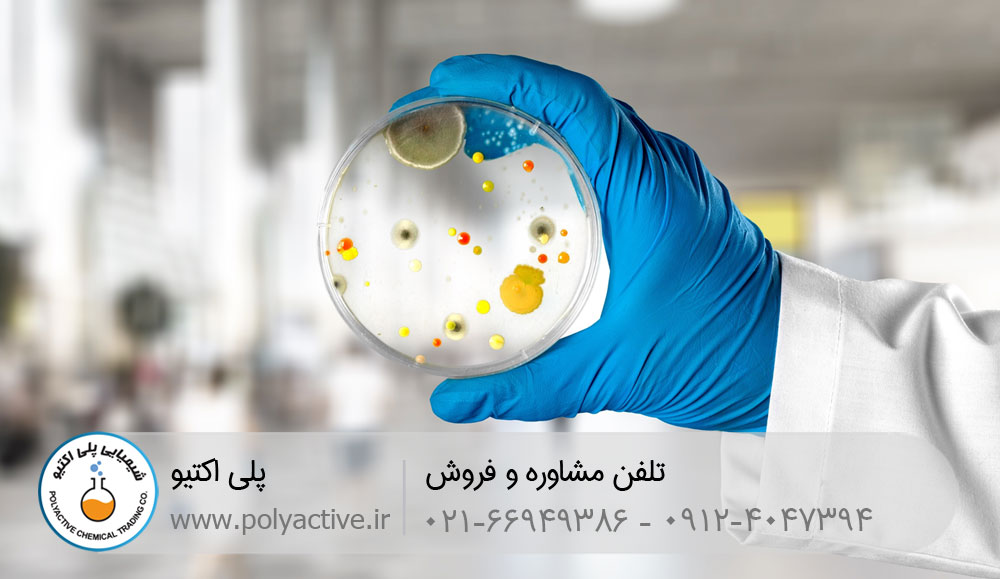
کاربر بایوساید در صنعت

تعریف بایوساید یا ضد کپک
بایوساید / Biocide محلولی است که به عنوان گند زدا و یا ضد کپک از آن یاد می شود. این ماده از رشد بی رویه میکروب های مضر در آب جلوگیری کرده و یا آن ها را در سطح مورد نظر نگه می دارد.
بایوسایدها در دو دسته اکسید کننده و غیر اکسیدی تقسیم بندی می شوند. عمده تفاوت این دو در ماهیت عملکردی آن است. در بایوساید اکسید کننده از بین بردن و تخریب میکروارگانیسم صورت می گیرد، اما در غیر اکسیدی، غشای سلول میکروارگانیسم های مضر حل می شود تا از بین برود.
میکروارگانیسم های هوازی و بی هوازی موجود در آب منجر به بروز بیماری های مختلف می گردد. از این رو لازم است به شیوه های مختلف کنترل و یا از بین بروند. بایوسایدها که موادی باکتری کش یا زیست کش هستند کمک زیادی در این زمینه می کنند.
ایزوتیازولین و کاربرد آن
احتمالا با این سوال روبرو شده باشید که ایزوتیازولین چیست و چه کاربردهایی دارید. ایزوتیازولین، گلوتارآلدئید و کلر به عنوان سه ماده مطرح بایوساید معرفی می شود که کاربردهای زیادی در صنعت دارند. از مشتقات ایزوتیازولین به طور گسترده به عنوان نگهدارنده ضد میکروبی یا بایوساید استفاده می شود. کنترل باکتری و جلبک های تشکیل دهنده لجن در سیستم های خنک کننده آب و فاضلاب و کاغذ سازی از کاربردهای رایج این ماده است. این ماده در غلطت های بالا می تواند باعث سوختگی شیمیایی و ایجاد سوزش در پوست و غشا شود. لازم به ذکر است که استفاده از ایزوتیازولین در تولید دترجنت و شوینده هایی مثل شامپو کاربردهای وسیعی دارد و می تواند از محصولات در برابر آلوده شدن به باکتری در محیط های مرطوب و خیس محافظت کند.
بایوساید در تصویه آب
رشد انواع جلبگ و قارچ در حوضچه های تصفیه آب مشکلات اساسی به وجود می آورد. انواع امراض پوستی و گوارشی حاصل این رویداد است.
بیوساید را میتواند به صورت مستقیم با اضافه کردن به آب و یا از طریق سیستمهای تصفیه ای اضافه نمود که مقدار و زمان آن بستگی به دستور العمل، نوع ماده شیمیایی و غلظت آلودگی آب دارد.

استفاده از بایوساید در صنعت نفت و گاز
میکروارگانیسم مضر سبب تخریب هیدروکربن های نفتی می شود که در اثر آن چگالی روغن بیشتر شده و ویسکوزیته افزایش می یابد. نتیجه این رویداد سبب اختلال در استخراج نفت و گاز می شود.
وجود میکروارگانسیم های مضر و بیش از حد نظیر هیدروژن سولفید (H2S) و دی اکسید کربن (CO2) سبب پدیده ترش شدن گاز می شود. این ترشی باعث خوردگی و فرسایش شدید تجهیزات انتقال و حفاری می شود. به منظور زدودن این مواد از گاز طبیعی از فرآیندی به نام شیرینسازی استفاده می کنند. حفاظت از تجهیزات و افزایش راندمان عملیاتی با کنترل خوردگی ناشی از میکروب به کمک بایوساید ضروری است.
کاربرد بایوساید در آب استخر
بقایای گیاهان حاوی جلبک و باکتری است که به کمک باد یا عوامل انسانی به آب استخر وارد می شود. هوای گرم و آفتابی و بی حرکت ماندن آب سبب شکوفا شدن جلبک و قارچ می شود. کلر، ازن و برم سه ماده موثر برای بهبود وضعیت و حفظ کیفیت آب استخر هستند. کلر را می توان به صورت مایع و قرص به آب اضافه نمود. امروزه برم جایگزین بهتری نسبت به کلر ضدعفونی است چرا که این ماده در محدوده pH وسیع تری نسبت به کلر عمل می کند.

گردش آب منظم، فیلتراسیون، تنظیم pH، استفاده از منعقد کننده نظیر زاج و استفاده از رنگ استخری ضد جلبک مواردی هستند که در عدم رشد و تکثیر و حذف ذرات و آلاینده های استخر موثر هستند.
راهنمای خرید بایوساید
تصفیه خانه آب و فاضلاب، صنایع نفت و گاز، نیروگاه، معادن، تولید رنگ و پوشش، کاغذ سازی از موارد پر کاربرد بایوساید و ضد کپک محسوب می شوند. اگر شما هم نیاز به استعلام، خرید و مشاوره این محصول دارید کافیست با شرکت شیمایی پلی اکتیو تماس و از مشاوره این مجموعه بهره مند شوید. تهیه محصولات شیمیایی به صورت عمده و جزئی امکان پذیر است. با ما در تماس باشید!
تلفن تماس: 02166949386 | 09124047394
وبسایت: https://www.polyactive.ir
این محتوا تبلیغاتی است




